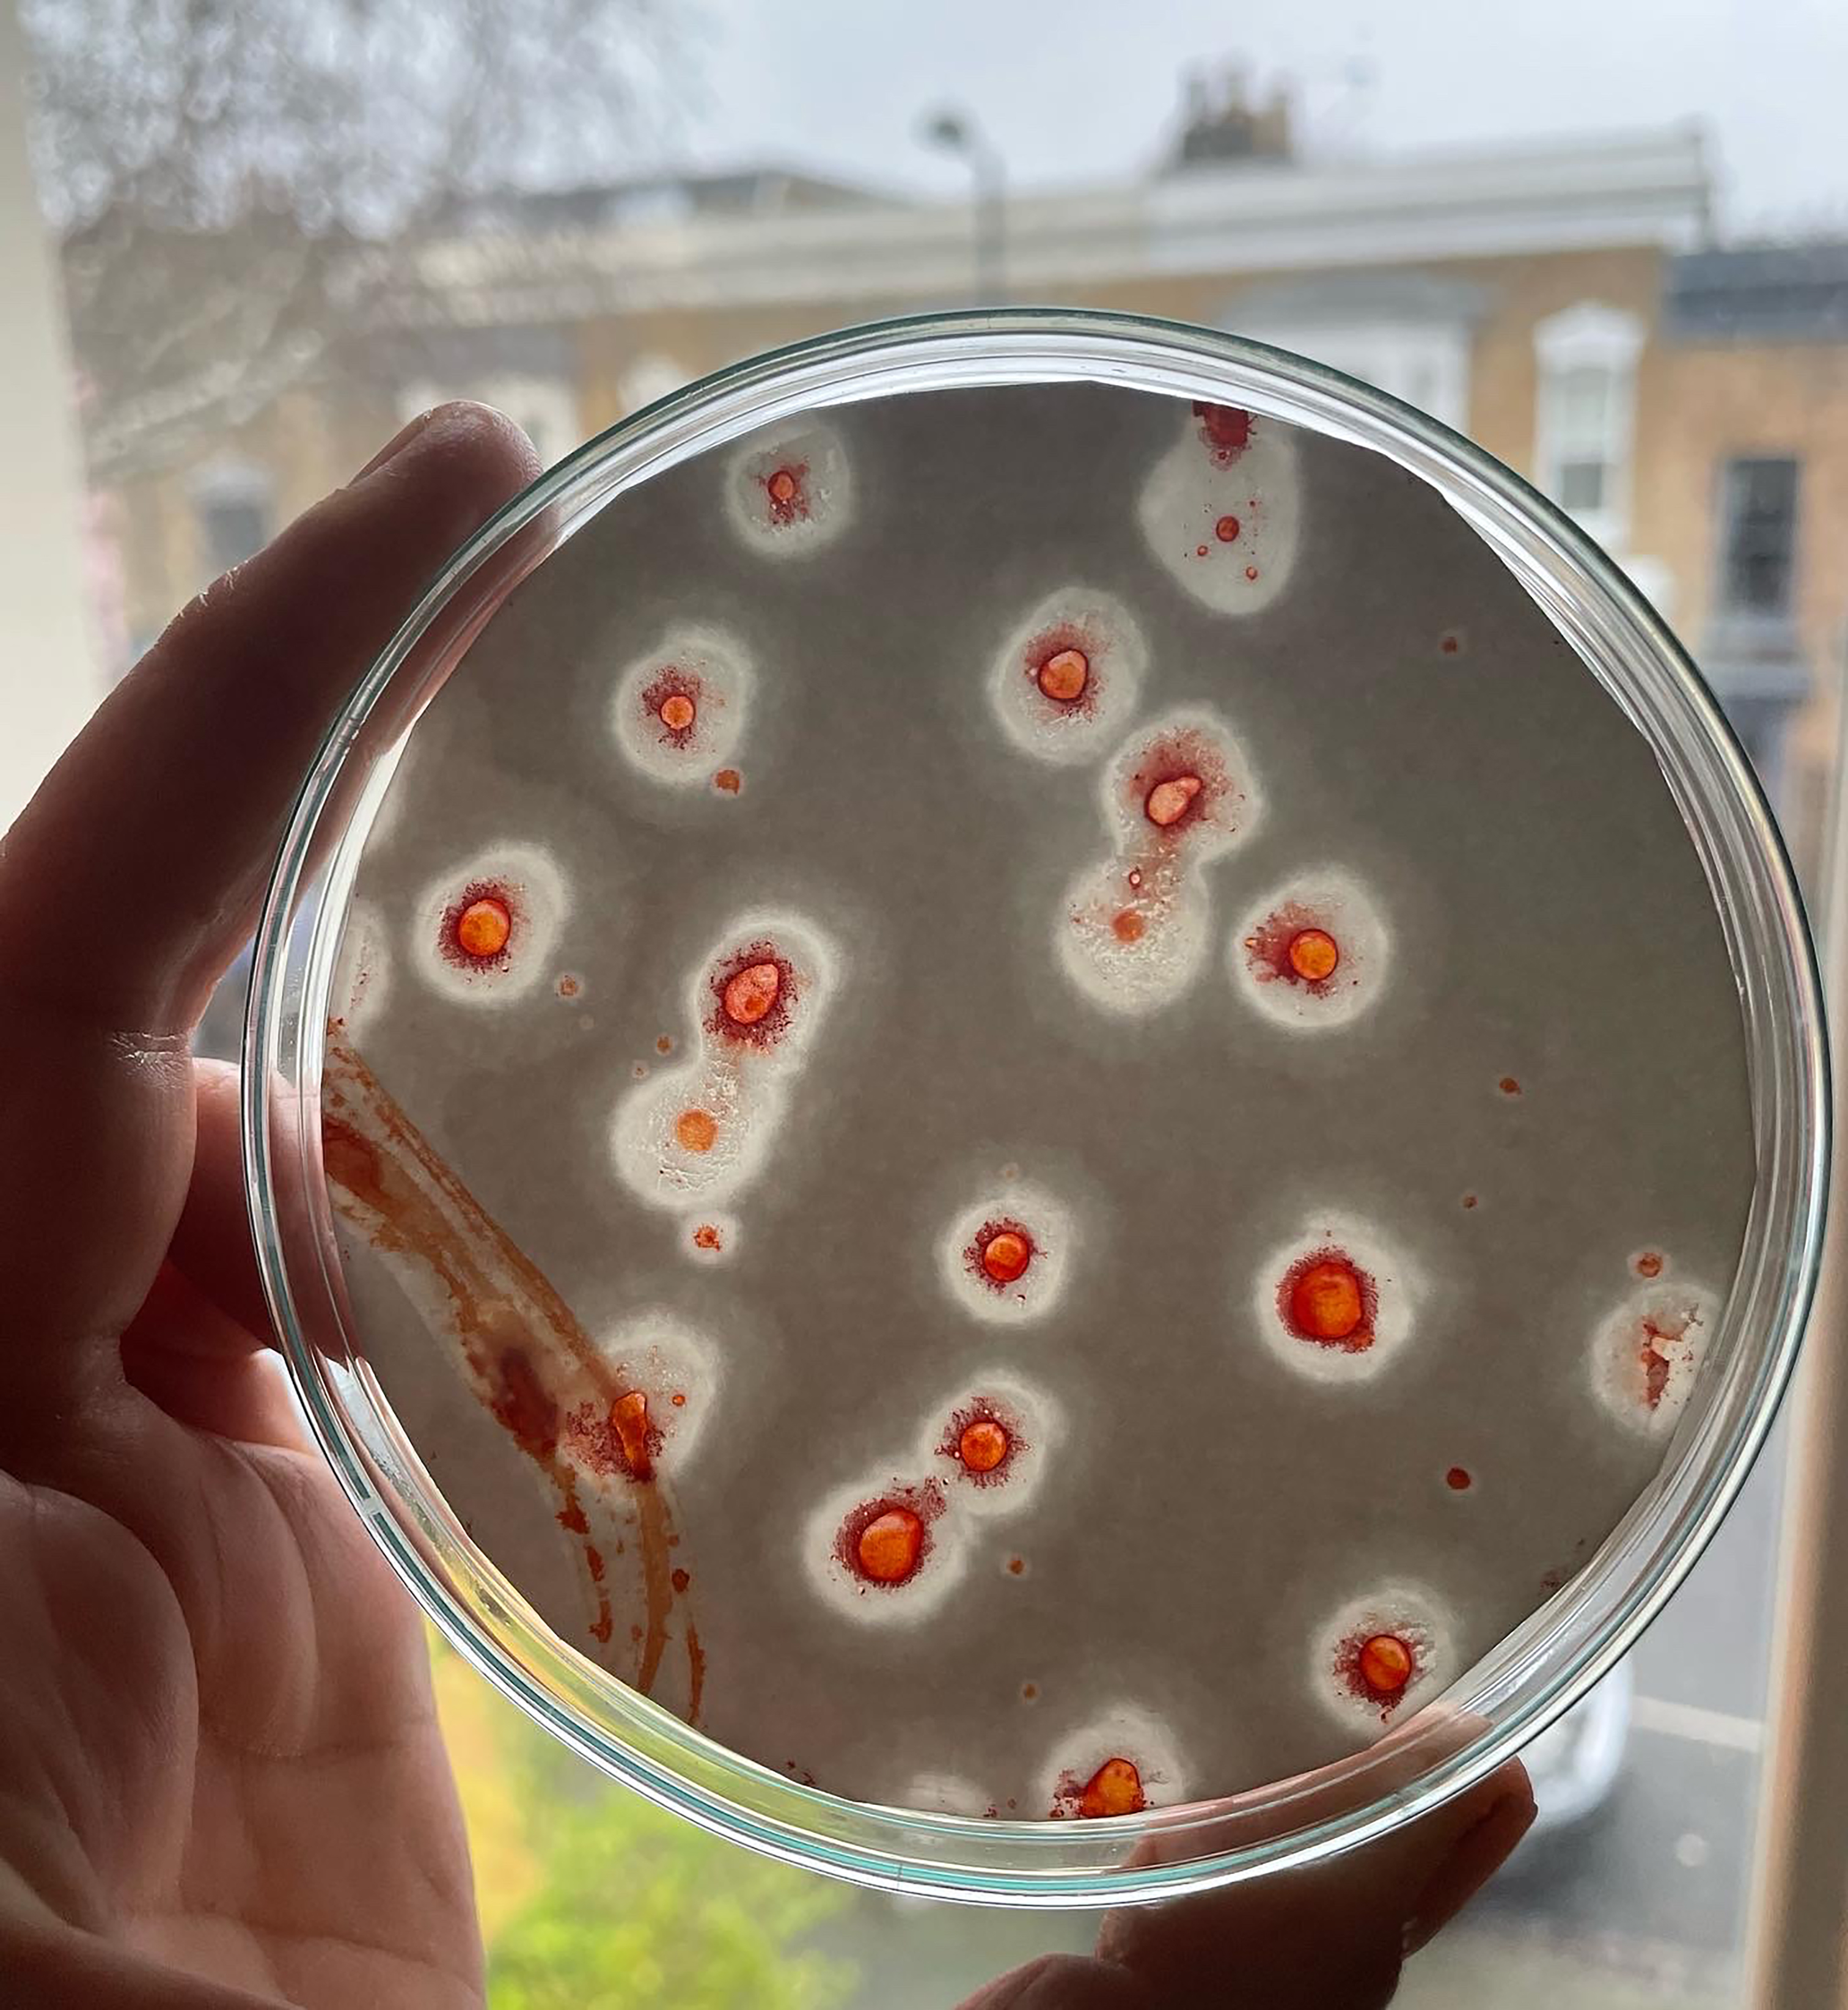

Ten Weeks of Fat
Design Research Residency at MA Design Goldsmiths in the 2022 Transfocality project: Ten weeks of Fat, in collaboration with Mike Thomson from Fatberg.
My involvement with the project, which invited students to explore with fat as a socio-cultural biological substance through a material, discursive and ethical practice, was a drawing experimentation using fat and ink. I explored how the agency of these substances informed the content of the drawings, whilst addressing issues related to the boundaries of the body, lipid cell representation, responses of disgust and of material fascination.